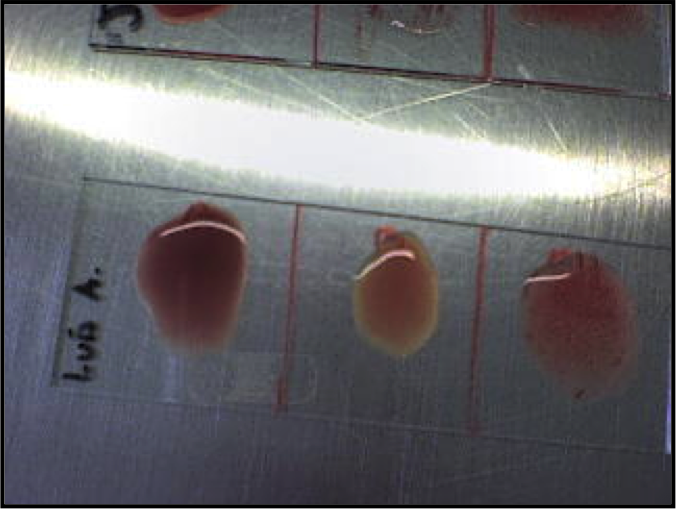

|
I need a paternity test, and fast
The virtual problem is about a paternity test. This test works with the blood group incompatibility, and the case helps you understand how this incompatibility works.
|
Teaching aims are:
- students need to get familiar with the concept of the blood groups,
- the hemagglutinins
- the hemaglutinogens
- the agglutination
- the hemolitic reactions
Authors: Gergely Jócsák, Tibor Bartha
|
|